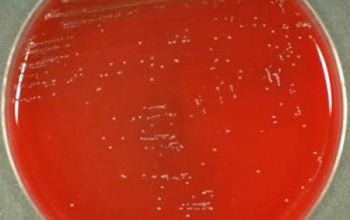
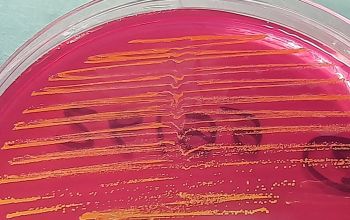

Leuconostoc mesenteroides
-
General information
Taxonomy
Family: Lactobacillaceae
Natural habitats
They can be isolated from plants, occasionally from milk and milk products.
Clinical significance
They can be isolated from the female genital tract, and the gastrointestinal tract.
Infectious for humans that have surgery, antibiotic therapy, or have impared immunological systems.
Leuconostoc is intrinsically resistant to vancomycin
-
Gram stain
Gram positive coccus
0.5-0.7 x 0.7-1.2 µm
occuring in pairs and chains.
Sometimes short rods with rounded ends in long chains.
-
Culture characteristics
-
Facultatief anaeroob
BA: they produce small, gray-whitish, alpha hemolytic or nonhemolytic colonies on blood agar.
Colony morphology resembles a Streptococcus.
BBAØ: growth
-
-
Characteristics
-
References
James Versalovic et al.(2011) Manual of Clinical Microbiology 10th Edition
Karen C. Carrol et al (2019) Manual of Clinical Microbiology, 12th Edition